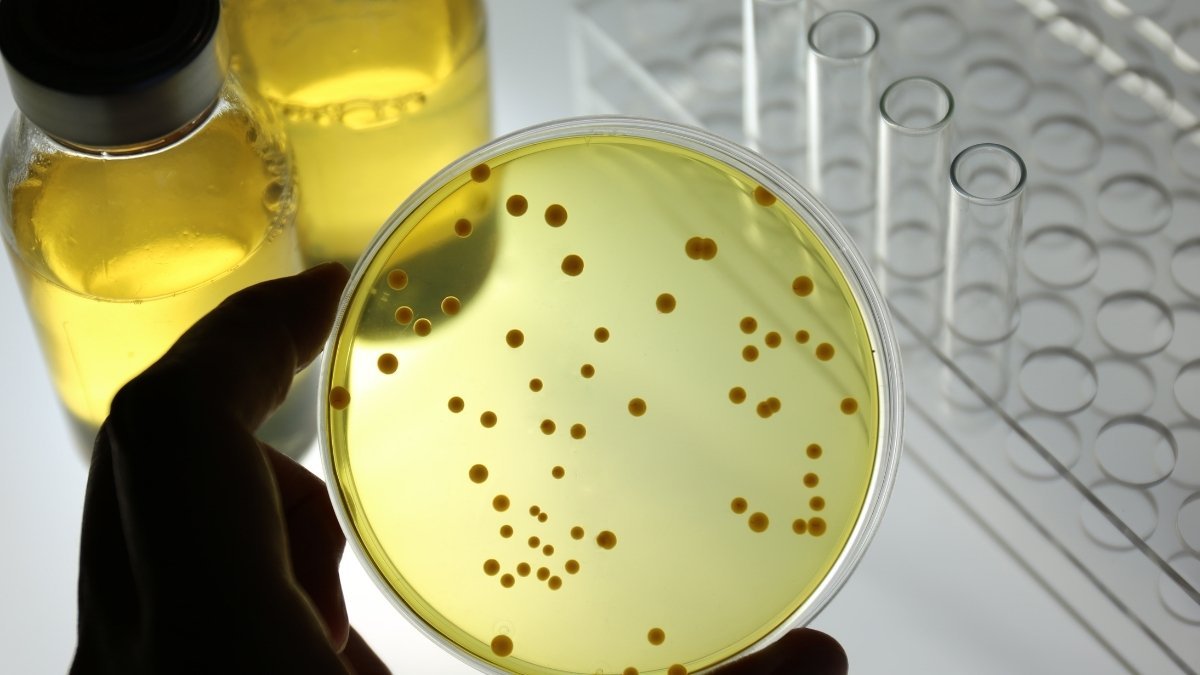
The Microbiological Penthouse You Can't Evict

Let’s be honest. When you hear the phrase “hand hygiene,” you probably tune out.
I get it. It feels… basic. We all know how to wash our hands, right? We’ve been doing it our entire lives. It’s the first thing we teach our kids. We scrubbed our hands raw through 2020. We know this.
But here’s the thing I’ve discovered, and it’s kind of unsettling: what if we’re all doing it wrong?
It turns out there’s a huge, invisible gap between thinking we have clean hands and actually having clean hands. And this gap isn’t just about whether we wash, but how, why, and what we’re using.
This is what I call the “Hand Hygiene Gap,” and the truth is, most of us are falling right into it.
As Dr. Arjun Venkatesh, the chair of emergency medicine at Yale Medicine, puts it, “The most common mistake made when it comes to handwashing is forgetting to do it in the first place; the second most common mistake is doing it so fast that you don’t get every part of both hands”.
That second part is the real kicker. We’re so confident in our technique that we’ve stopped paying attention. And we’re all missing the same spots.
So, Where Are We All Going Wrong?

This isn’t just a guess. This is a “Technique Gap” that researchers have measured.
They’ll do these studies where they coat participants’ hands in a fluorescent gel and then just say, “Go wash your hands like you normally would.” When the person comes back, they stick their “clean” hands under a scanner.
The results are… not great.
A 2019 study found that a staggering 48.1% of people completely failed to wash their fingertips properly. And it’s not just them. The CDC (Centers for Disease Control and Prevention) specifically warns that even healthcare providers “frequently miss” three key areas: Thumbs, Fingertips, and between fingers.
Think about your own handwashing. We kind of just rub our palms together, maybe get the backs, and call it a day. But those missed areas? They’re the parts of your hand that actually interact with the world. Your fingertips and thumbs are what you use for your “pincer grip”—the very tools you use to touch elevator buttons, keyboards, your phone, and, most critically, your eyes, nose, and mouth.
We are systematically neglecting the exact parts of our hands that are most likely to pick up and pass on germs.
🧼 Hand Hygiene “Blind Spots” 🎯
The most frequently missed areas during a “normal” handwash, based on clinical studies.
Action Item: Focus on scrubbing these areas next time you wash your hands!
The Microbiological Penthouse You Can’t Evict
So, why is missing your fingertips (which nearly half of us do) such a massive deal?
I’m about to ruin your day. I’m sorry.
It’s because of a tiny, specific anatomical feature: the “subungual space.”
That’s the clinical term for that tiny, protected sliver of real estate under your fingernails. It’s not just “dirty.” It’s a microbiological penthouse for germs. It is described in microbiological literature as the place that “harbors the most microorganisms and is most difficult to clean”.
And the numbers are staggering.
Studies on presurgical hand preparation (we’re talking 10-minute medical scrubs) found that even before scrubbing, the subungual area can have bacterial counts as high as 190,000 to 950,000 colony-forming units (CFUs) under a single nail.
Here’s the truly terrifying part: a different study found that even after a full 10-minute surgical scrub, “neither of the two methods tested reduced the microbial population under the fingernails… to ‘acceptable’ levels”.
If a surgical scrub can’t fully clean it, your 10-second rinse with a splash of soap doesn’t stand a chance.
This is why things like artificial fingernails and even rings are a known problem. Germs can live under them both before and after washing or using sanitizer.
Now, to be clear, the goal isn’t to sterilize your hands. That’s impossible, and you wouldn’t want to. Your hands have “resident flora,” which are the good-guy germs that live there and protect your skin.
The real goal of handwashing is to mechanically remove the “transient flora.” These are the dangerous hitchhikers—the germs you pick up from a doorknob or a contaminated surface—that are “responsible for most health care–associated infections”.
Luckily, these transient germs are “easily removed by mechanical means”. But you have to actually do the mechanical part.
The Great Sanitizer Misunderstanding

Okay, this is the big one. The “Knowledge Gap.”
The COVID-19 pandemic rewired our brains. We all became obsessed with hand sanitizer. We have bottles in our cars, on our desks, in our bags. And for an enveloped virus like SARS-CoV-2, alcohol-based hand rub (ABHR) is a fantastic tool.
But we’ve been trained to see it as a magic, all-purpose bullet. It’s not.
Relying on it 100% of the time is a huge mistake because soap and sanitizer are not interchangeable. They don’t even work the same way.
- How Soap Works: Structural Demolition is a work of chemical genius. Its molecules have two ends: a “head” that loves water and a “tail” that hates water but loves fats and oils.. Many viruses (like Coronaviruses and the flu) and bacteria are wrapped in a fatty (lipid) layer. The soap molecules act like “crowbars”; their tails wedge themselves into that fatty layer and literally rip the virus or bacteria apart, destroying them. Then, the friction of you rubbing your hands lifts all that destroyed-germ-and-dirt-goo off your skin, and the water just rinses it all away. It’s a demolition and removal job.
- How Sanitizer Works: Chemical Warfare Alcohol-based sanitizer (with 60%-95% alcohol 18) works by “brute force”. It’s a “rapidly germicidal” agent 19 that kills germs by dissolving their membranes and “denaturing” their proteins. (Fun fact: 100% alcohol is less effective. It needs a little water, which is “critical in the protein denaturation process”.
Here’s the problem: Sanitizer only works on some germs and in some conditions.
This is the “Sanitizer Gap”:
- It Fails on Visibly Dirty Hands: If your hands are greasy or visibly dirty (think after gardening, playing sports, or eating greasy food), the alcohol can’t get through all that gunk to kill the germs. Soap and water are designed to lift that grease and dirt off. Sanitizer is not.
- It Fails on Chemicals: Sanitizer kills germs. It does not remove substances. If you’ve been handling pesticides or heavy metals, sanitizer does nothing. Soap and water will remove them.
- It Fails on the Wrong Pathogens (This is the most important one): Sanitizer is great against enveloped viruses. But it is terrible against germs that don’t have that fatty envelope.
Soap and water are “more effective than hand sanitizers” at removing these specific, nasty germs 18:
- Norovirus (That famously contagious “stomach flu” that rips through offices and cruise ships)
- Clostridium difficile (or C. diff) (A dangerous spore-forming bacterium that causes severe, often hospital-acquired, colitis)
- Cryptosporidium (A waterborne parasite that causes diarrheal disease)
In fact, one study found that routine use of hand sanitizer was linked to an increased risk of Norovirus outbreaks.
We’ve all been trained to be “sanitizer-first.” But if you’ve been in a public place (especially a bathroom or hospital) or around someone with a stomach bug, reaching for the sanitizer instead of the sink is the wrong move.
🦠 Hand Hygiene Cheat Sheet 💦
The “When-to-Use-What” Simple Breakdown
The “Why Bother?” Problem

So, we’re bad at the how (the Technique Gap) and confused about the what (the Knowledge Gap). But what about the why? Why are we all… slacking off?
If you feel like you’ve been letting your guard down since the peak of the pandemic, you are not alone. It’s a real, measurable trend called “hygiene fatigue”.
We were all hyper-vigilant. Now, we’re just… tired.
And the data proves it. A major 2024/2025 study tracked this collapse in real-time in hospitals.
- During the Pandemic (Oct 2021–Jan 2023): Hand hygiene compliance was high, at 90.27%.
- Post-Pandemic (Feb 2023–Jul 2024): After the emergency was downgraded, compliance significantly dropped to 82.56%.
- The Consequence: What happened at the same time? Healthcare-associated infections (HAIs) significantly rose from 16.79 per mille ($\permil$) to 18.71 per mille ($\permil$).
That’s the smoking gun. As a group, we got tired, our compliance dropped, and as a direct result, more people got sick.
The Post-Pandemic “Hygiene Fatigue” Effect
Data from 2021-2024 shows a clear link: when attention on hygiene drops, infection rates climb.
Phase 1: Pandemic Control
Timeframe: Oct 2021 – Jan 2023
Hand Hygiene (HH) Compliance Rate
90.27%
HAI Incidence
16.79‰
The Shift
HH Compliance
↓7.71%
(P < 0.001)
HAI Incidence
↑1.92‰
(P < 0.001)
Phase 2: Post-Pandemic Downgrade
Timeframe: Feb 2023 – Jul 2024
Hand Hygiene (HH) Compliance Rate
82.56%
HAI Incidence
18.71‰
This fatigue is powered by two other psychological quirks.
- The “It Won’t Be Me” Bias: This is simple “relative overconfidence”. We all tend to believe we are “better than the median of a group”. We hear “people are bad at handwashing” and think, “Yeah, other people are.” This overconfidence impairs our behavior in daily routines.
- The “Role Model Gap”: This one is fascinating. Studies in hospitals found that medical students explicitly said they “copy the behavior of their superiors”. Why were the superiors non-compliant? Because they didn’t believe the evidence was strong enough. Hand hygiene, it turns out, is a socially transmitted behavior. If the boss cuts corners, the team cuts corners.
The Modern Loophole That’s Undoing All Your Work

Okay, let’s say you do everything right. You avoid the “Technique Gap,” you know when to use soap, and you fight off “Hygiene Fatigue.”
You can still mess it all up in five seconds.
This is the “Situational Gap”: we’re applying old hygiene rules to a modern world that has vectors our grandparents never dreamed of. I’m talking about your smartphone.
It’s a “high-touch surface” that’s basically a third, unwashed hand. A University of Arizona study found that most cellphones carry 10 times the bacteria of the average toilet seat.
And we know they’re gross. One 2018 study of healthcare workers found that while two-thirds suspected their phones fostered bacteria, “nearly 90 percent never clean their phones”.
This creates the “hygiene loophole”.
Think about it: You’re in a public restroom. You wash your hands perfectly. You use a paper towel to open the door. You feel great. Then, you pull out your phone, which was sitting on the counter or in your hand before you washed.
Game over.
Your surgically clean hands are instantly re-contaminated by the “digital fomite” you carry with you everywhere. All that effort, wasted.
And don’t even get me started on the “Glove Gap”—the false belief that wearing gloves means your hands are clean. Gloves are vectors, not barriers. The WHO is clear: you use one pair for one patient, and remove them before touching anything else. They are just another surface to move germs from one place to another.
The 175-Year-Old Argument We’re Still Having

This whole problem—this resistance—feels so modern. But it’s not. We’ve been having this same fight for over 175 years.
Back in 1846, a Hungarian doctor in Vienna named Ignaz Semmelweis was haunted by a mystery. In his hospital, there were two maternity wards.
- Ward 1 was run by doctors and medical students. Maternal mortality was ~16%.
- Ward 2 was run by midwives. Mortality was ~2%.
He couldn’t figure out why. Then he had a breakthrough. He realized the doctors and students were coming to the maternity ward directly from the autopsy room.
He hypothesized that “cadaverous particles” (his 1840s term for germs) were on their hands, being passed to the mothers.
His solution: He mandated handwashing with a chlorinated lime solution.
The results were immediate and staggering. The death rate in his ward plummeted to below 2%. He proved, definitively, that handwashing saves lives.
And for this, he was… rejected. His discovery “was not popular”.
Why? Because, as one source notes, doctors were “disgruntled that Semmelweis was implying that they were to blame for the deaths”. They “stopped washing their hands”. He was mocked, rejected, and professionally ruined, only to be proven right decades later by Pasteur and the development of germ theory.
This is the “Semmelweis Echo.” The primary barrier to hand hygiene has never been a lack of evidence. It’s been ego. It’s the senior doctor who still thinks the evidence isn’t strong enough. It’s our own “overconfidence” that we couldn’t possibly be the problem.
We are still that disgruntled doctor, refusing to believe that something so simple could be our own undoing.
How to Actually Close the Gap (Starting Today)

Okay, so we’re all a bit humbled. The good news is, we can fix this. The solution is just to be mindful. The goal isn’t just to “do it,” but to “do it well“.
The World Health Organization (WHO) has a 6-step handwashing protocol designed specifically to defeat the “Technique Gap.” It should take 40-60 seconds (longer than you think!).
Here are the rubbing steps. Don’t just read them—mime them right now.
- Palm to palm. (Easy, we all do this).
- Right palm over left back with interlaced fingers (and vice versa). (This gets the back of the hands and in-between the fingers).
- Palm to palm with fingers interlaced. (This really gets between the fingers.)
- Backs of fingers to opposing palms with fingers interlocked. (This gets the backs of your knuckles).
- Rotational rubbing of the left thumb clasped in the right palm (and vice versa). (This is the Thumb Gap-closer!).
- Rotational rubbing, backwards and forwards, with clasped fingers of the right hand in the left palm (and vice versa). (This is the Fingertip & Subungual Gap-closer!).
When you use hand sanitizer, the steps are the same, just without water. The whole process should take 20-30 seconds—you must rub until your hands are completely dry. Don’t wave them around; the friction and time are part of the process.
And Finally… Let’s Bust Some Myths

Let’s clear up the last bits of the “Knowledge Gap.”
- Myth 1: You need hot water to kill germs.MYTH. This is the big one. The CDC is clear: Warm and cold water remove the same number of germs. Water’s job is to create the lather and rinse germs away, not to kill them (it would have to be scalding hot to do that 52). In fact, hot water is worse because it causes skin irritation, making you less likely to wash your hands at all.
- Myth 2: “Antibacterial” soap is better.MYTH (for consumers). The FDA has stated there is “no added health benefit” for consumers using soaps with antibacterial ingredients (like triclosan) versus plain soap. Plain ol’ soap and water work perfectly.
- Myth 3: My hands look clean, so they are clean.MYTH. This is the whole point. The germs that make you sick are microscopic. A single gram of human feces (about the weight of a paper clip) can contain one trillion germs. You can’t see the “transient flora” you’re carrying.
- Myth 4: Hand sanitizer causes antibiotic resistance.MYTH. This is a dangerous confusion. Alcohol-based sanitizers “do not create antimicrobial-resistant germs”. Alcohol kills germs with a rapid, physical “denaturing” process, which is totally different from how antibiotics work.
A Few Tools to Help Close the Gaps
Okay, I know we just spent all this time talking about technique, but let’s be real: having the right tools can make a huge difference. It’s just easier to build a good habit when you remove the little points of friction. Here are a few things I’ve found that directly tackle the gaps we talked about.
1. A Touchless Soap Dispenser.

Think about it: what’s the first thing you touch before you wash your hands? The germy soap pump. A touch-free dispenser eliminates that one little moment of cross-contamination. The Simplehuman sensor pumps are a popular example; they’re rechargeable and have a silicone valve that snaps shut to prevent messy drips.
2. A Soap That Doesn’t Wreck Your Skin.

If your hands are cracked and dry, you’re going to avoid washing them. The key is to use plain soap that’s also incredibly gentle. Dermatologists often recommend cleansers like CeraVe or Aveeno because they contain ingredients like ceramides, hyaluronic acid, or colloidal oatmeal to help restore the skin’s barrier, not strip it.
3. A Soft Nail Brush.

This is the official tool for the “Subungual Gap.” Remember that impossible-to-clean “microbiological penthouse” under your fingernails? The CDC actually recommends scrubbing the underside of your nails with a nail brush every time you wash. You don’t need anything harsh; a simple, soft-bristled brush used with soap and water is all it takes to mechanically clean out that critical, often-missed area.
4. A UV-C Phone Sanitizer.

This one directly tackles the “hygiene loophole.” What’s the point of washing your hands perfectly if you immediately grab your phone, which can carry 10 times more bacteria than a toilet seat? These UV-C light boxes are designed to disinfect your phone’s surfaces without using harsh chemicals. You just drop it in, close the lid, and let the light (which should be in the correct nanometer range) do its work.
5. A Good Hand Cream (Not Just a Scented Lotion).

This isn’t just for comfort; it’s a critical part of hygiene. Dry, cracked skin actually makes it easier for germs to get into your body. The American Academy of Dermatology recommends applying a thick cream or ointment immediately after your hands dry from washing or sanitizing to lock in moisture. Look for heavy-duty restorers with ingredients like shea butter or ceramides.
It’s Not Just You, It’s All of Us
Look, the “Hand Hygiene Gap” isn’t really a personal failure. It’s a cultural one. We’re all over-confident, a little bit tired, and defaulting to social norms that are, frankly, pretty unhygienic.
The solution, then, has to be cultural, too. A 2024 report from The Leapfrog Group found that the percentage of U.S. hospitals meeting high-end hand hygiene standards “soared from 11% to 74% by 2023”.
This magic leap didn’t come from more posters. It came from a 78% rise in hospitals “holding leadership directly accountable” for hygiene, often tying it to their performance reviews or pay.
That’s the “Semmelweis Echo” finally being answered. When the leaders model the right behavior—when it becomes part of the system—the culture changes.
For the rest of us, it starts with closing our own gap. It’s about having the humility to admit that maybe, after all these years, we could learn to wash our hands just a little bit better.
